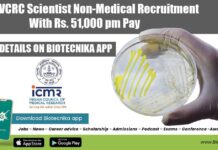
ICMR-VCRC Scientist Non-Medical Recruitment With Rs. 51,000 pm Pay VCRC Job Vacancies 2022

Govt Pharmacopoeia Commission for Indian Medicine & Homoeopathy Recruitment
PCIM&H Jobs 2022 - Biotech, Biochem, Life Sciences, Mol Bio Walk-In
PCIM&H Jobs 2022 - Biotech, Biochem, Life Sciences, Mol Bio Walk-In. Microbiology Jobs. Botany...
How To Use NCERT Textbooks For NEET Chemistry Preparation For Guaranteed Success
NCERT Textbooks For NEET Chemistry
How To Use NCERT Books For Guaranteed Success in NEET
National Eligibility-cum-Entrance Test (NEET) conducted by the National Testing Agency...
GAT-B/BET 2022 Results Declared – Download Scorecard
GAT-B/BET 2022 Results Declared - Download Scorecard
GAT-B/BET 2022 Results Declared - Download Scorecard. GAT-B 2022 Results have been declared. BET 2022 results have been...
Biotecnika Times Newsletter 27.05.2022 IISc Intern With Stipend, ICMR-VCRC Scientist, Pfizer
Biotecnika Times - IISc Intern With Stipend, ICMR-VCRC Scientist, Pfizer
DST-Centre for Policy Research-IISc Project Intern With Up to Rs. 12,000 pm Pay
IISc Project Intern...
FSSAI Director Recruitment 2022 – Applications Invited
FSSAI Director Recruitment 2022 - Applications Invited
FSSAI Director Recruitment 2022 - Applications Invited. Deputation jobs at FSSAI 2022. Interested and eligible applicants can check...
Amrita Vishwa Vidyapeetham Develops World’s First Synthetic Jaw-Bone Graft, Gets Govt. Nod For Clinical...
Amrita Vishwa Vidyapeetham Press Release
Amrita Vishwa Vidyapeetham develops world’s first
synthetic jaw-bone graft,
gets Govt. nod for clinical trial
The project is funded by Dept of...
ICAR-NAARM Life Sciences Research Associate Job With Rs. 50,000 pm Pay
ICAR-NAARM Life Sciences Research Associate Job With Rs. 50,000 pm Pay
ICAR-NAARM Life Sciences Research Associate Job With Rs. 50,000 pm Pay. ICAR--National Academy of...
IRRI Project Associate Job For Biology & Biochemistry, Apply Online
IRRI Project Associate Job For Biology & Biochemistry, Apply Online
IRRI Project Associate Job For Biology & Biochemistry, Apply Online. BSc & MSc Biotechnology, Biology...
ICGEB Biofuel Group Life Science, Biotech, Mol Bio Research Jobs 2022
ICGEB Research Vacancies 2022 - MSc, MTech & PhD Apply
ICGEB Research Vacancies 2022 - MSc, MTech & PhD Apply. MSc, MTech & PhD Life...
Shiv Nadar University JRF Job For Biotech & Biochem, Apply Online
SNU JRF Vacancy 2022 For MSc Biotech, Biochem - Apply Online
SNU JRF Vacancy 2022 For MSc Biotech, Biochem - Apply Online. Shiv Nadar University...
DST-Centre for Policy Research-IISc Project Intern With Up to Rs. 12,000 pm Pay
IISc Project Intern Opening - Rs. 12,000 pm Pay, Apply Online
IISc Project Intern Opening - Rs. 12,000 pm Pay, Apply Online. MSc Life Sciences...
C-CAMP Life Sciences Scientist Job Openings, Applications Invited
C-CAMP Life Sciences Scientist Job Openings, Applications Invited
C-CAMP Life Sciences Scientist Job Openings, Applications Invited. C-CAMP Life Sciences Translation Postdoctoral Scientist and Senior Translation...
Amity AIMMSCR Noida Project Job For Biology & Biotech, Apply Online
Amity AIMMSCR Noida Project Job For Biology & Biotech, Apply Online
Amity AIMMSCR Noida Project Job For Biology & Biotech, Apply Online. MSc Biotech, Biology...
Microbiology Job at Pfizer – Candidates With 0-4 Years Exp Apply Online
Microbiology Job at Pfizer - Candidates With 0-4 Years Exp Apply Online
Microbiology Job at Pfizer - Candidates With 0-4 Years Exp Apply Online. Pfizer...
ICMR-VCRC Scientist Non-Medical Recruitment With Rs. 51,000 pm Pay
VCRC Job Vacancies 2022 - MSc & PhD Life Sciences, Biotech Apply
VCRC Job Vacancies 2022 - MSc & PhD Life Sciences, Biotech Apply. PhD...